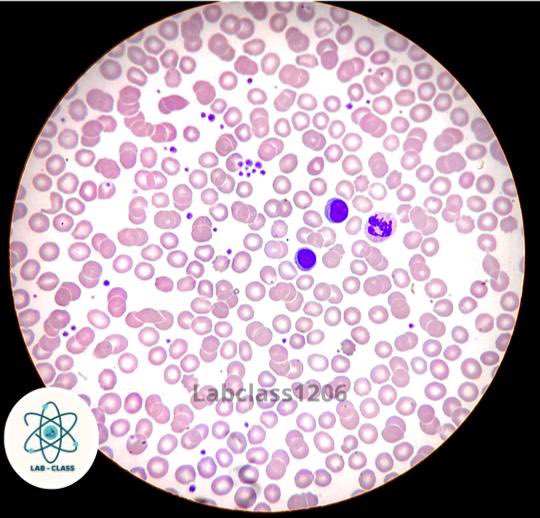
LabClass1206's tweet image. Linfocitos, segmentado, agregado plaquetario… 
¿Qué mas observas en la imagen? 

#hematologia #frotis #laboratorio #microscópio

LabClass
@LabClass1206
Análisis clínicos 👩🏽🔬🦠🩸💉🧬💊🧫
You might like
Crónicas matutinas de trabajar enfrente de una escuela 8:02. Carreras mamás, papás y alumnos para que los dejen entrar. Cierran el porton*
Un día como hoy, en 1896, Henri Becquerel descubrió por casualidad un fenómeno totalmente nuevo. Perdió interés en el tema y se lo pasó a una estudiante polaca. Marie Curie supo estudiarlo y sacarle partido a ese fenómeno, que bautizó como radiactividad. bit.ly/2IK0WGo

Linfocitos, segmentado, agregado plaquetario… ¿Qué mas observas en la imagen? #hematologia #frotis #laboratorio #microscópio
Tapón azul El anticoagulante que se utiliza es el citrato sódico apropiado para el estudio de la coagulación de la sangre. #laboratorio #laboratory #laboratorioclinico #lab #anticoagulante

Blastocystis spp. es el protista intracelular que se detecta con mayor frecuencia en muestras de materia fecal humana; las tasas de infección pueden superar el 20% en países en vías de desarrollo. Este parásito en heces de diversas especies animales sugiere su potencial zoonótico

La transfusión de sangre es la transferencia de la sangre o un componente sanguíneo de una persona a otra. #donacion #hematologia #pruebascruzadas #laboratorio #donarsalvavidas #donarsangreesdonarvida

La hemostasia es un mecanismo de defensa del organismo que se activa tras haber sufrido un traumatismo o lesión que previene la pérdida de sangre del interior de los vasos sanguíneos. #laboratorio #hematologia #inmunologia #uroanalisis #parasitologia #hemostasia

United States Trends
- 1. Michigan 108K posts
- 2. Jeremiah Smith 5,383 posts
- 3. Ryan Day 4,633 posts
- 4. #TheGame 3,474 posts
- 5. Malachi Toney 1,407 posts
- 6. Stoops 2,165 posts
- 7. Buckeyes 8,229 posts
- 8. #GoBlue 7,822 posts
- 9. Bo Jackson 1,345 posts
- 10. Sayin 88.1K posts
- 11. Barham 1,717 posts
- 12. Donaldson 1,670 posts
- 13. Arvell Reese N/A
- 14. Touchback 5,208 posts
- 15. Florida 104K posts
- 16. Texas 192K posts
- 17. #OSUvsMICH N/A
- 18. Clemson 5,169 posts
- 19. Kentucky 17.8K posts
- 20. #GoBucks 5,058 posts
You might like
Something went wrong.
Something went wrong.



























